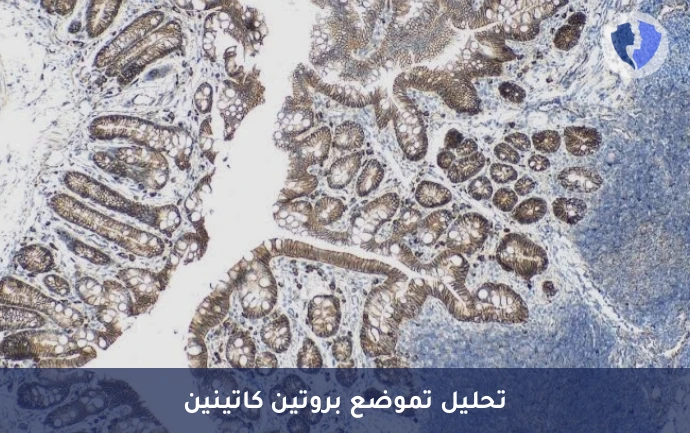
كشف العيوب الجينية بالأورام - تحليل الكيمياء النسيجية المناعية لبروتين بيتا كاتينين (β-Catenin)

تفاصيل الخدمة
كشف العيوب الجينية بالأورام - تحليل الكيمياء النسيجية المناعية لبروتين بيتا كاتينين (β-Catenin)
فحص كيميائي مناعي نسيجي (IHC) يقيّم نمط التعبير والتوطين داخل الخلية لبروتين بيتا-كاتينين (β-Catenin). في الحالة الطبيعية، يوجد بيتا-كاتينين في الغشاء الخلوي (مرتبطاً بالإيكادهيرين) وفي السيتوبلازم. في حالات الطفرات المُفعّلة في جين CTNNB1 (المشفر لبيتا-كاتينين) أو في مسار Wnt، يتراكم البروتين في النواة وينتقل إليه. يُستخدم هذا التحليل كعلامة تشخيصية للأورام المرتبطة بطفرات مسار Wnt/β-catenin، وأهمها ورم الأرومة الليفية الليفي (Desmoid Fibromatosis)، كما أنه مفيد في أورام الكبد مثل الورم الغدي الكبدي (Hepatocellular Adenoma) وأنواع فرعية من سرطان الكبد، وفي بعض أورام الجهاز الهضمي.